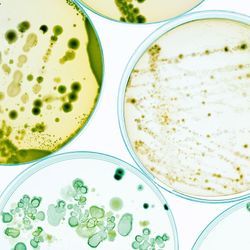
Regulating Blood Glucose via the Gut Microbiome Regulating Blood Glucose via the Gut Microbiome

Fecal Microbiota Transplant: An Emerging Therapeutic Frontier
Fecal microbiota transplants may offer new hope for a range of difficult-to-treat health conditions

Humans have coevolved with microbial ecosystems since our ancestors’ earliest interactions with their environments, so our interdependence with these microscopic organisms is hardly surprising. However, our understanding of the health benefits and consequences resulting from these dynamic relationships is still in its infancy.
Recent clinical studies have demonstrated changes in the gut microbiota not only in gastrointestinal (GI) conditions such as inflammatory bowel disease (IBD) and irritable bowel syndrome (IBS), but also in rheumatoid arthritis, autism and depression, and various other conditions. These wide-reaching associations have inspired novel therapeutic approaches to address the microbiome’s role in health. Perhaps most notable of these microbiome-based therapies is the fecal microbiota transplant (FMT), which aims to replace a patient’s disease-associated “dysbiotic” microbiota with a healthy microbiota. In doing so, the treatment ideally mitigates direct and indirect microbial contributions to the pathology at hand. Though there are still substantial challenges concerning FMT, successful adoption of this technique has the potential to revolutionize our approach to a myriad of diseases.
As it stands, FMT treatment has not been approved for any specific indications through the FDA’s Investigational New Drug application pipeline. However, studies have shown that FMT can cure up to 90 percent of patients with recurrent Clostridioides difficile infections (CDI). With widespread acknowledgment of the treatment’s efficacy in refractory cases, in 2016 the FDA approved the use of FMT to treat CDI under conditions that ensure patient safety and consent. CDI is characterized by an overabundance of an opportunistic pathogen in the colon along with known changes in other bacterial families, making it an ideal candidate for FMT treatment. However, FMT efficacy in conditions with less consistent changes in the gut microbiota remains an active area of investigation.
Broader applications to gut health
In recent years, dramatic increases in intestinal conditions including IBD and IBS have been reported. Though patients present with various forms of these conditions, investigators frequently observe reduced diversity of the patient’s gut microbiota. If reduced microbial diversity indeed contributes to common GI symptoms of IBD and IBS, then FMT treatment could offer relief for GI patients by replenishing their microbial populations.
Data from two recent clinical trials assessing FMT efficacy in IBD patients with ulcerative colitis showed sustained clinical responses in 51 percent of patients at three months post-FMT. Additionally, in 2019 the first placebo-controlled clinical trial in IBS patients led by Dr. Magdy El-Salhy at Stord Hospital in Norway concluded that FMT treatment reduced symptoms in up to 89 percent of patients. With early evidence of success, clinical investigators will continue to refine FMT delivery methods and protocols, and further assess wider applications for FMT.
Looking beyond the gut
A swath of emerging data has now linked the gut microbiota to diseases that manifest outside of the GI tract. Autoimmune diseases such as rheumatoid arthritis have complex genetic and environmental influences that include distinct abnormalities of the gut microbiota, and preclinical studies in mice suggest that specific bacterial species can trigger arthritis. Led by Dr. Xuan Zhang of Peking Union Medical College Hospital in Beijing, recruitment is under way for a placebo-controlled Phase 2 clinical trial examining FMT efficacy in rheumatoid arthritis. Successful FMT treatment could signal a new therapeutic approach for a number of different autoimmune disorders.
Exciting new research has also highlighted critical signaling pathways between the gut and brain, termed the gut–brain axis. Though a number of hypotheses attempt to explain how the gut microbiota may influence psychiatric health, it is clear that the two are related. Individuals with autism spectrum disorders (ASD) are commonly plagued with GI symptoms and have an altered gut microbiota, leading many to speculate that gut bacteria may influence this subset of developmental disorders. A small open-label clinical trial led by Dr. Rosa Krajmalnik-Brown of Arizona State University found that FMT treatment reduced both GI and ASD-behavioral symptoms in 18 ASD-diagnosed children. Re-evaluation of the cohort after two years indicated that the subjects maintained increased bacterial diversity and reduced GI and ASD-behavioral symptoms. These promising early results suggest the need for larger double-blinded placebo-controlled trials to further assess FMT in ASD-diagnosed individuals.
Obstacles ahead
As with any new treatment modality, patient safety is of paramount concern and demands the attention of regulatory oversight. This is especially true of FMT treatment due to the potential transfer of pathogens from donor to recipient. Thus, it is critical that donor qualifications and screening methods are carefully considered. Potential donors are subjected to medical interviews that alert clinicians to inflammatory conditions, risk-associated behaviors, and any history of medication that may alter the gut microbiota. Those with permissive medical histories are further screened via blood chemistry analysis, serology, and stool testing for transmittable pathogens.
Despite these considerable precautions, FMT treatment is not without risk. In early 2020, the FDA detailed adverse reactions in six patients that were treated for recurrent CDI. The recipients developed infections with enteropathogenic and Shiga toxin-producing E. coli after receiving FMT from two donors, resulting in the hospitalization of several patients. More broadly, clinicians will also need to consider the emergence of novel threats like SARS-CoV-2 to FMT recipients, which require further protections. In response to the risk posed by the pandemic, last April the FDA released guidelines for increased screening of donors to minimize the potential of coronavirus transmission. These cases outline the potentially severe consequences of failed pathogen detection during the screening process, and demonstrate that public health agencies will have an integral role in the safe use of FMT.
As scientists race to uncover new links between the microbiome and human health, interest in microbiome-based therapies will continue to rise. FMT represents an entirely new angle of attack against many conditions that are difficult to manage using current treatments, signaling renewed hope for patient relief. Treatment protocols will certainly evolve as we learn more about microbial influences on health, FMT has already ushered in a new generation of more personalized approaches to medicine.